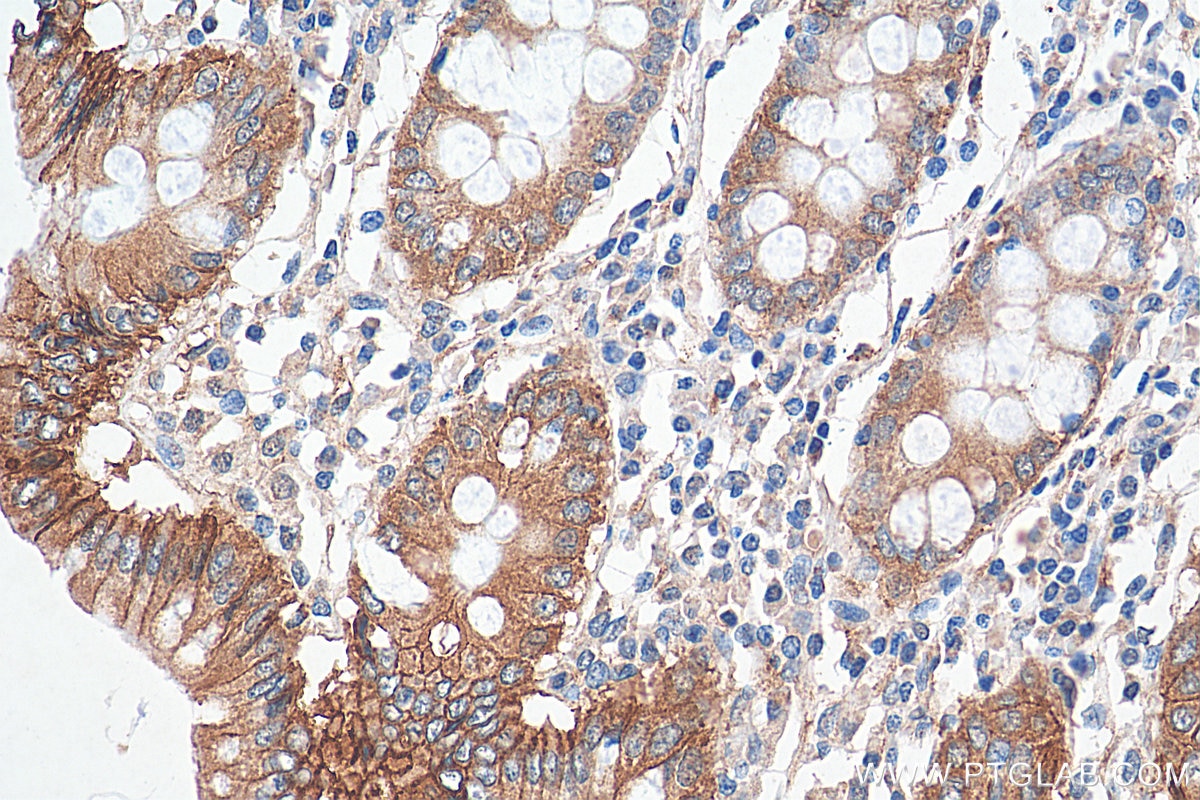
IHC staining of human colon using 17565-1-AP Immunohistochemistry (IHC) staining of human colon tissue using Beta Catenin Polyclonal antibody (17565-1-AP)
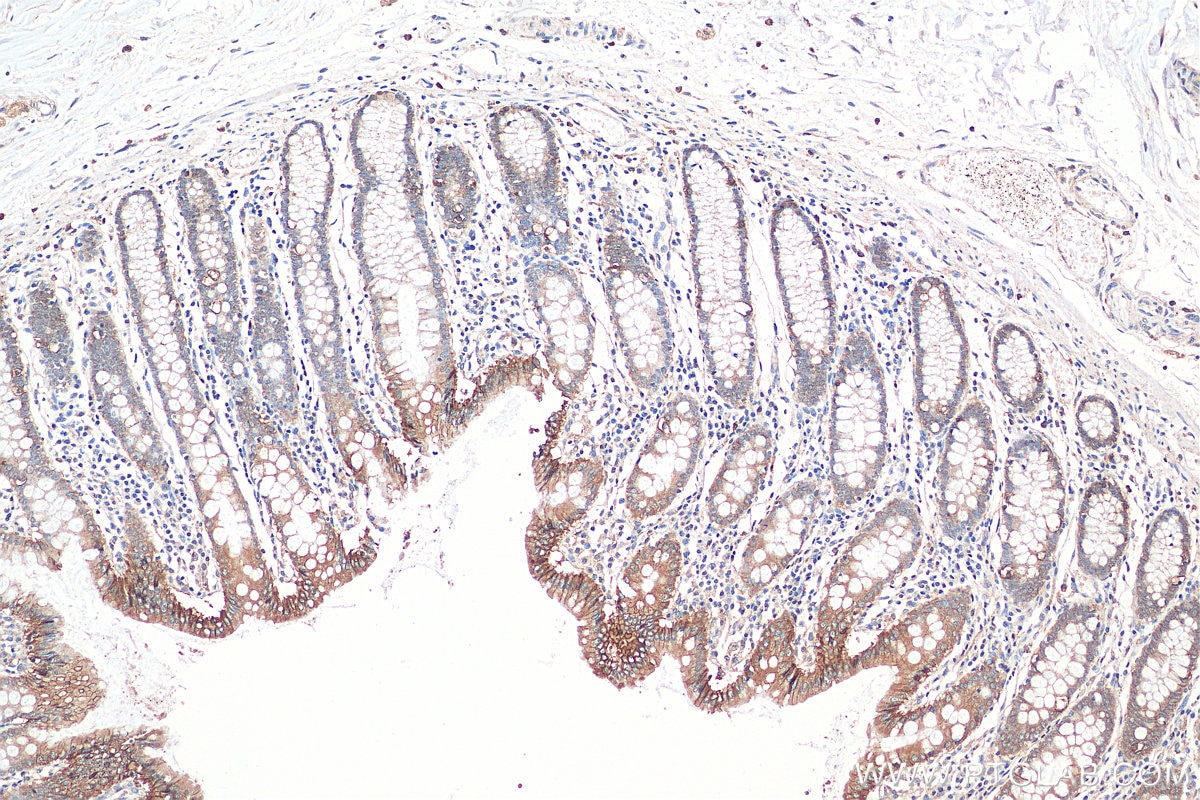
IHC staining of human colon using 17565-1-AP Immunohistochemistry (IHC) staining of human colon tissue using Beta Catenin Polyclonal antibody (17565-1-AP)

Tested Applications
| Positive WB detected in | HEK-293 cells, A431 cells, mouse brain tissue, NIH/3T3 cells, rat brain tissue, HeLa cells, C6 cells, mouse liver tissue, rat liver tissue |
| Positive IP detected in | HEK-293 cells |
| Positive IHC detected in | human liver cancer tissue, human breast cancer tissue, human colon tissue Note: suggested antigen retrieval with TE buffer pH 9.0; (*) Alternatively, antigen retrieval may be performed with citrate buffer pH 6.0 |
| Positive IF/ICC detected in | MCF-7 cells, T-47D cells, U-251 cells, U-87 MG cells |
| Positive FC (Intra) detected in | MCF-7 cells |
Recommended dilution
| Application | Dilution |
|---|---|
| Western Blot (WB) | WB : 1:2000-1:16000 |
| Immunoprecipitation (IP) | IP : 0.5-4.0 ug for 1.0-3.0 mg of total protein lysate |
| Immunohistochemistry (IHC) | IHC : 1:50-1:500 |
| Immunofluorescence (IF)/ICC | IF/ICC : 1:200-1:800 |
| Flow Cytometry (FC) (INTRA) | FC (INTRA) : 0.40 ug per 10^6 cells in a 100 µl suspension |
| It is recommended that this reagent should be titrated in each testing system to obtain optimal results. | |
| Sample-dependent, Check data in validation data gallery. | |
Published Applications
| KD/KO | See 2 publications below |
| WB | See 120 publications below |
| IHC | See 23 publications below |
| IF | See 38 publications below |
| IP | See 3 publications below |
| CoIP | See 1 publications below |
Product Information
17565-1-AP targets Beta Catenin in WB, IHC, IF/ICC, FC (Intra), IP, CoIP, ELISA applications and shows reactivity with human, mouse, rat samples.
| Tested Reactivity | human, mouse, rat |
| Cited Reactivity | human, mouse, rat, pig |
| Host / Isotype | Rabbit / IgG |
| Class | Polyclonal |
| Type | Antibody |
| Immunogen |
CatNo: Ag11763 Product name: Recombinant human B-catenin protein Source: e coli.-derived, PGEX-4T Tag: GST Domain: 433-781 aa of BC058926 Sequence: KNKMMVCQVGGIEALVRTVLRAGDREDITEPAICALRHLTSRHQEAEMAQNAVRLHYGLPVVVKLLHPPSHWPLIKATVGLIRNLALCPANHAPLREQGAIPRLVQLLVRAHQDTQRRTSMGGTQQQFVEGVRMEEIVEGCTGALHILARDVHNRIVIRGLNTIPLFVQLLYSPIENIQRVAAGVLCELAQDKEAAEAIEAEGATAPLTELLHSRNEGVATYAAAVLFRMSEDKPQDYKKRLSVELTSSLFRTEPMAWNETADLGLDIGAQGEPLGYRQDDPSYRSFHSGGYGQDALGMDPMMEHEMGGHHPGADYPVDGLPDLGHAQDLMDGLPPGDSNQLAWFDTDL Predict reactive species |
| Full Name | catenin (cadherin-associated protein), beta 1, 88kDa |
| Calculated Molecular Weight | 781 aa, 86 kDa |
| Observed Molecular Weight | 92 kDa |
| GenBank Accession Number | BC058926 |
| Gene Symbol | Beta Catenin |
| Gene ID (NCBI) | 1499 |
| ENSEMBL Gene ID | ENSG00000168036 |
| RRID | AB_2088102 |
| Conjugate | Unconjugated |
| Form | Liquid |
| Purification Method | Antigen affinity purification |
| UNIPROT ID | P35222 |
| Storage Buffer | PBS with 0.02% sodium azide and 50% glycerol, pH 7.3. |
| Storage Conditions | Store at -20°C. Stable for one year after shipment. Aliquoting is unnecessary for -20oC storage. 20ul sizes contain 0.1% BSA. |
Background Information
β-Catenin, also known as CTNNB1, is an evolutionarily conserved, multifunctional intracellular protein. β-Catenin was originally identified in cell adherens junctions (AJs) where it functions to bridge the cytoplasmic domain of cadherins to a-catenin and the actin cytoskeleton. Besides its essential role in the AJs, β-catenin is also a key downstream component of the canonical Wnt pathway that plays diverse and critical roles in embryonic development and adult tissue homeostasis. The Wnt/β-catenin pathway is also involved in the activation of other intracellular messengers such as calcium fluxes, JNK, and SRC kinases. Deregulation of β-catenin activity is associated with multiple diseases including cancers. (PMID: 22617422; 18334222)
Protocols
| Product Specific Protocols | |
|---|---|
| FC protocol for Beta Catenin antibody 17565-1-AP | Download protocol |
| IF protocol for Beta Catenin antibody 17565-1-AP | Download protocol |
| IHC protocol for Beta Catenin antibody 17565-1-AP | Download protocol |
| IP protocol for Beta Catenin antibody 17565-1-AP | Download protocol |
| WB protocol for Beta Catenin antibody 17565-1-AP | Download protocol |
| Standard Protocols | |
|---|---|
| Click here to view our Standard Protocols |
Publications
| Species | Application | Title |
|---|---|---|
J Clin Invest JAM3 maintains leukemia-initiating cell self-renewal through LRP5/AKT/β-catenin/CCND1 signaling. | ||
Adv Sci (Weinh) LIMA1 O-GlcNAcylation Promotes Hepatic Lipid Deposition through Inducing β-catenin-Regulated FASn Expression in Metabolic Dysfunction-Associated Steatotic Liver Disease | ||
Cell Death Dis USP8 positively regulates hepatocellular carcinoma tumorigenesis and confers ferroptosis resistance through β-catenin stabilization | ||
Mater Today Bio A novel adhesive dual-sensitive hydrogel for sustained release of exosomes derived from M2 macrophages promotes repair of bone defects | ||
Br J Pharmacol Reregulation of hepatic stellate cell contraction and cirrhotic portal hypertension by Wnt/β-catenin signaling via interaction with Gli1. | ||
Oncogene β-Catenin interacts with canonical RBPs including MSI2 to associate with a Wnt signalling mRNA network in myeloid leukaemia cells |